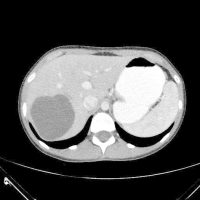
Εχινόκοκκος Κύστη

Ο ορθοκολικός καρκίνος αποτελεί το 3ο πιο συχνό κακόηθες νεόπλασμα στις Δυτικές κοινωνίες. Ηπατικές μεταστάσεις
αναπτύσονται στο 50% των ασθενών
αυτών και είναι υπεύθυνες για τα 2/3 των θανάτων. Η μόνη μέθοδος αντιμετώπισης των ασθενών με ορθοκολικό καρκίνο και μεταστάσεις ήπατος, με δυνητική θεραπεία είναι η ηπατεκτομή. Η 5ετής επιβίωση μετά από ηπατεκτομή ποικίλει από 25% μέχρι 60% και είναι σημαντικά μεγαλύτερη από αυτήν στους ασθενείς που δεν δύνανται να υποβληθούν σε ηπατεκτομή που είναι 0% με 5%. Δυστυχώς το μεγαλύτερο ποσοστό των ασθενών με ορθοκολικό καρκίνο και μεταστάσεις ήπατος δεν έχουν ένδειξη ηπατεκτομής. Η στενή συνεργασία των εξιδεικεύμενων χειρουργών ήπατος με τους ογκολόγους έχει σαν αποτέλεσμα την μετατροπή πολλών ανεγχείρητων περιπτώσεων μεταστάσεων ήπατος σε εξαιρέσιμες. Η χρήση νεώτερων σχημάτων χημειοθεραπείας σε συνδυασμό με στοχευμένους παράγοντες έχουν αυξήσει σημαντικά το ποσοστό των ασθενών με δυνητικά χειρουργήσιμη νόσο.
Τα τελευταία χρόνια με την πρόοδο στις χειρουργικές τεχνικές του ήπατος, την πρόοδο στην αναισθησιολογία, τη χρήση νέας προηγμένης τεχνολογίας διεγχειρητικά (CUSA, προηγμένες μορφές ενέργειας, RFA, διεγχειρητικό υπερηχογράφημα) έχει οδηγήσεις σε αύξηση του ποσοστού των ηπατεκτομών με παράλληλα μείωση των διεγχειρητικών και λοιπών επιπλοκών και σχεδόν μηδενισμού των περιεγχειρητικών θανάτων. Ο προεγχειρητικός Εμβολισμός της Πυλαίας Φλέβας (Portal Vein Embolization) είναι μία τεχνική που χρησιμοποιούμαι εδώ και πολλά χρόνια με αποτέλεσμα την αύξηση των ηπατεκτομών και τη βελτίωση της ασφάλειας των ασθενών.
Οι ασθενείς με ηπατικές μεταστάσεις από ορθοκολικό καρκίνο χωρίζονται σε τρεις βασικές κατηγορίες.
- Ασθενείς με εξαιρέσιμη νόσο
- Ασθενείς με δυνητικά εξαιρέσιμη νόσο
- Ασθενείς με ανεγχείρητη νόσο
Σε όλες τις παραπάνω κατηγορίες ασθενών προηγείται Ογκολογικό Συμβούλιο και κατόπιν προτείνεται η καταλληλότερη αντιμετώπιση σύμφωνα πάντα με τις πιο σύγχρονες κατευθυντήριες οδηγίες (Guidelines)
Ι) Ασθενείς με εξαιρέσιμη νόσο
Συνίσταται η απευθείας χειρουργική εκτομή (Ηπατεκτομή) ή μικρής διάρκειας προεγχειρητική χημειοθεραπεία (Neo-adjuvant Chemotherapy) προ της ηπατεκτομής. Στις περιπτώσεις που το τμήμα του ήπατος που θα παραμείνει είναι μικρότερο του 25-35% (Future Liver Remnant) γίνεται προεγχειρητικά Εμβολισμός της Πυλαίας Φλέβας
ΙΙ) Ασθενείς με δυνητικά εξαιρέσιμη νόσο
Συνίσταται η μακρά και ισχυρή προεγχειρητική χημειοθεραπεία, η επανασταδιοποίηση του ασθενούς και η επιλογή της ηπατεκτομής όταν πλέον η νόσος καταστεί εξαιρέσιμη. Και εδώ στις περιπτώσεις που το τμήμα του ήπατος που θα παραμείνει είναι μικρότερο του 25-35% (Future Liver Remnant) γίνεται προεγχειρητικά Εμβολισμός της Πυλαίας Φλέβας
ΙΙΙ) Ασθενείς με ανεγχείρητη νόσο
Οι ασθενείς με ανεγχείρητη νόσο παραπέμπονται για χημειοθεραπεία, στοχευμένες θεραπείες, ακτινοβολία, RFA ή ότι άλλο κριθεί κατάλληλο από το ογκολογικό συμβούλιο. Περιοδικά επανασταδιοποιούνται για αξιολόγηση της κατάστασης του και την τροποποίηση της θεραπείας αν κριθεί αναγκαίο
Εργαστηριακή και Απεικονιστική διερεύνηση των ασθενών με μεταστάσεις ήπατος από ορθοκολικό καρκίνο. Οι εξετάσεις που γίνονται είναι:
- Αιματολογικές και Βιοχημικές εξετάσεις
- Καρκινικοί Δείκτες (CEA, CA 19-9, aFP)
- Υπερηχοτομογραφία (Κλασική και Διεγχειρητική)
- Τριφασική Αξονική Τομογραφία (Triphasic MDCT)
- Μαγνητική Τομογραφία με Γαδολινούχο Σκιαγραφικό (Enhanced MRI)
- Σύνθεση Τομογραφίας Ποζιτρονίων και Αξονικής Τομογραφίας (18-FDG-PET/CT)
- Σπινθηρογράφιμα
Είδη Ηπατεκτομών
Ανατομικές ηπατεκτομές
- Δεξιά Ηπατεκτομή (Τμήματα 5 έως 8, SV-SVIII)
- Δεξιά Εκτεταμένη Ηπατεκτομή (Τμήματα 4 εώς 8, SIV-SVIII)
- Δεξιά Πλάγια Ηπατεκτομή (Τμήματα 6 εώς 7, SVI-SVII)
- Αριστερά Πλάγια Ηπατεκτομή (Τμήματα 2 εώς 3, SII-SIII)
- Αριστερά Ηπατεκτομή (Τμήματα 2 εώς 4, SII-SIV)
- Αριστερά Εκτεταμένη Ηπατεκτομή (Τμήματα 2 εώς 5 + 8, SII-SV+SVIII)
- Κεντρική Ηπατεκτομή
Τμηματεκτομές – Εκτομές Μεταστάσεων
Λαπαροσκοπικές Ηπατεκτομές
Ρομποτικές Ηπατεκτομές